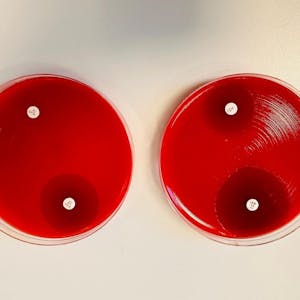
Image for the Antimicrobial resistance - theory and methods course

Antimicrobial resistance - theory and methods
$49
ENROLL NOWCourse Overview
Antimicrobial resistance is an increasingly pressing global concern. This course offers unique and comprehensive insights into the challenges posed by AMR, exploring its mechanisms, implications for public health and laboratory methods as well as tools for identification. Participants gain learning experience on how bacteria become resistant and which mechanisms lead to the outcome of resistance. As part of the course, you will also receive demonstration and training in methods for antimicrobial susceptibility testing (AST) and detection of specific resistance in the microbiological laboratories. Additionally, it will take you through various techniques employed including culture-based methods such as agar dilution and disk diffusion assays which determine the susceptibility of bacteria to antibiotics. Molecular methods such as polymerase chain reaction (PCR) and whole genome sequencing are also outlined in detail equipping you with basic understanding. These methods provide valuable insights into the prevalence and mechanisms of AMR, aiding in the development of effective treatment strategies and surveillance programs. In our new version an additional module including detection of specific resistance mechanisms has been incorporated.
Course FAQs
What are the prerequisites for 'Antimicrobial resistance - theory and methods'?
Prerequisites for this continuing education class are set by Technical University of Denmark (DTU). Most professional development online classes benefit from some prior knowledge. Please check the provider's page for specific requirements.
Will I receive a certificate for this CE class?
Yes, upon successful completion, Technical University of Denmark (DTU) typically offers a shareable certificate to showcase your new skills and fulfill your continuing education requirements.
How long does this online course take to complete?
Completion times for online continuing education courses vary. The provider's website will have the most accurate estimate of the time commitment needed.





